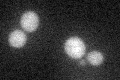
YBR006W
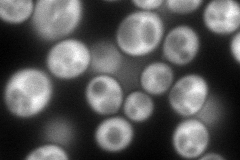
YBR006W
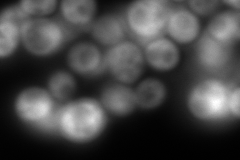
YBR006W
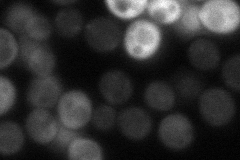
YBR006W
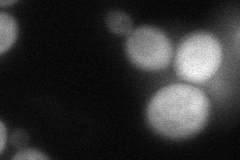
YBR006W
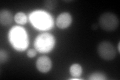
YBR006W
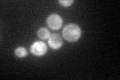
YBR006W

View description
Succinate semialdehyde dehydrogenase involved in the utilization of gamma-aminobutyrate (GABA) as a nitrogen source; part of the 4-aminobutyrate and glutamate degradation pathways; localized to the cytoplasm
Localization:
Intensity:
Fold change:
Significance:
-
C’ GFP library in SD
cytosol38.15 -
N' NOP1pr-GFP in SD
cytosol197.332 -
N' TEF2pr-mCherry in SD
cytosolN/A -
N' NATIVEpr-GFP in SD
punctate46.4573 -
N' TEF2pr-VC and Cyto-VN in SD
cytosol86.1551 -
C’ GFP library in SD+DTT
cytosol71.611.87Yes -
C’ GFP library in SD+H2O2

cytosol44.661.17No -
C’ GFP library in Starvation Media
cytosol120.123.14Yes -
C’ GFP library on the background of Pup2-DaMP

cytosol -
C’ GFP library on the background of CCT mutant

cytosol51.06521.33829No
